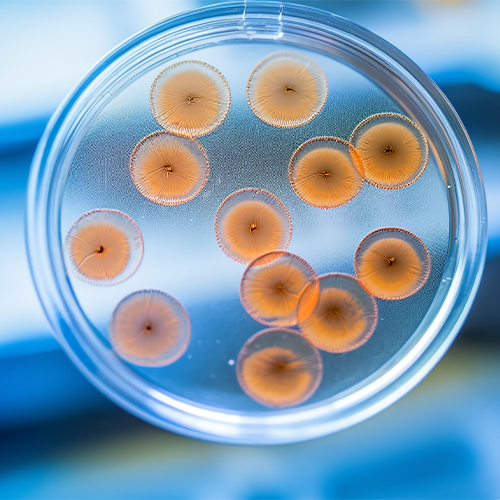
MICB蛋白-ACROBiosystems百普赛斯

MICB蛋白-ACROBiosystems百普赛斯
MICB
询价
100ug
起订
500ug
起订
1000ug
起订
北京 更新日期:2026-04-03
产品详情:
- 中文名称:
- MICB蛋白
- 英文名称:
- MICB
- 品牌:
- 百普赛斯
- 产地:
- 北京
- 保存条件:
- -20°C to -70°C
- 纯度规格:
- 99.9%
- 产品类别:
- 重组蛋白
- 货号:
- MICB
- 用途范围:
- 药物开发等
- 规格:
- 100ug
- 是否进口:
- 否
公司简介
百普赛斯集团ACROBiosystems Group(股票代码:301080)是成立于2010年的跨国生物科技公司,是为全球生物医药、健康产业领域提供关键生物试剂产品及解决方案的行业平台型基石企业。2021年在创业板上市。百普赛斯集团业务遍布全球,横跨亚洲、北美洲、欧洲,在中国、美国、瑞士等12个城市设有办公室、研发中心及生产基地。目前累计服务客户超6000家,与全球Top 20医药企业均建立了长期、稳定的合作伙伴关系。集团旗下拥有品牌ACROBiosystems百普赛斯、bioSeedin柏思荟、Condense Capital垦拓资本和ACRODiagnostics百斯医学等。
| 成立日期 | (16年) |
| 注册资本 | 8000万人民币 |
| 员工人数 | 500人以上 |
| 年营业额 | ¥ 1亿以上 |
| 经营模式 | 工厂,试剂 |
| 主营行业 | 医药中间体,原料药,激素类,氨基糖苷类,中枢神经系统用药 |
MICB蛋白相关厂家报价
-

- MICB抗体;MICB Antibody—艾普蒂
- 上海切尔齐生物科技有限公司
- 2025-05-25
- 询价
-

- HumanⅠ类MHC多肽相关序列B(MICB) ELISA Kit
- 上海博尔森生物科技有限公司 VIP
- 2026-04-23
- ¥3104
-

- 白蛋白(ALB)重组蛋白
- 上海泽叶生物科技有限公司 VIP
- 2026-04-23
- ¥2460
-

- Anti-MICB antibody-MICB抗体
- 上海沪震实业有限公司 VIP
- 2026-04-23
- ¥1138